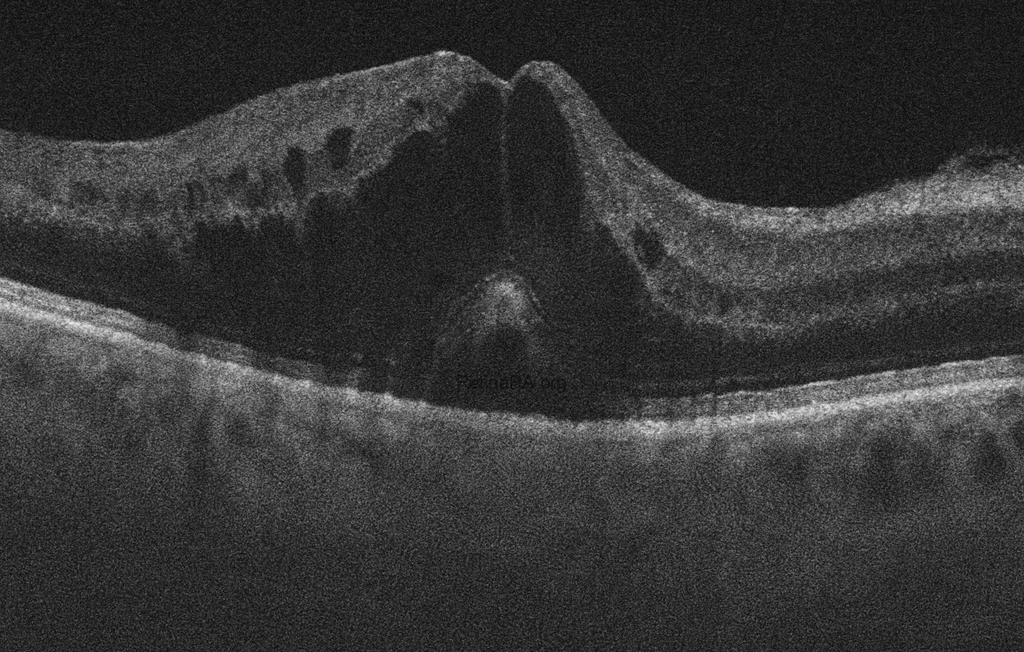
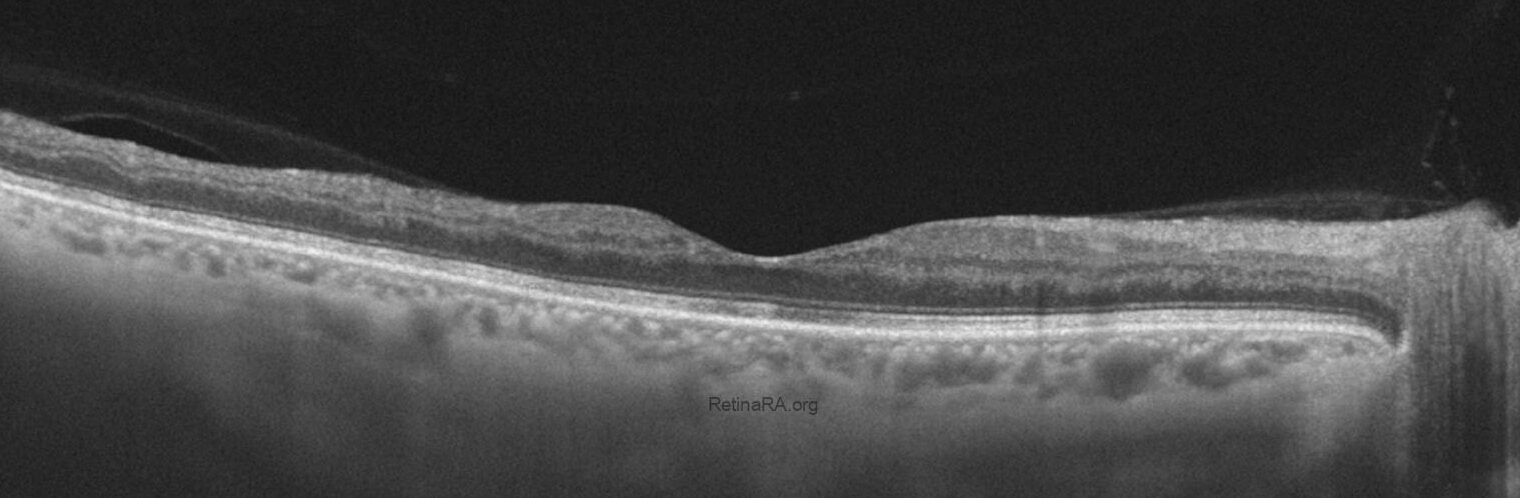

A 66-year-old male presented with complaints of sudden blurred vision in his right eye. His past medical history was notable for only hypertension, for which he was receiving oral antihypertensive medications.
On ophthalmic examination, best-corrected visual acuity was 0.3 in the right eye and 1.0 in the left eye. Anterior segment findings were unremarkable in both eyes, and intraocular pressure was within normal limits. Fundus examination of the right eye revealed widespread intraretinal hemorrhages in all four quadrants, dilated and tortuous retinal veins, and cotton wool spots consistent with central retinal vein occlusion (CRVO). The left eye appeared normal.
The color fundus photograph demonstrates the classic features of central retinal vein occlusion. There are widespread intraretinal hemorrhages involving all four quadrants, producing the characteristic “blood and thunder” appearance. The retinal veins are markedly dilated and tortuous, reflecting venous congestion. The macular region is involved with hemorrhages and appears thickened, suggesting the presence of macular edema. Overall, the retina appears hazy because of diffuse edema, and the retinal arterioles are relatively attenuated compared with the engorged venous system.

The fundus autofluorescence (FAF) image shows a heterogeneous pattern with multiple areas of hypo- and hyperautofluorescence scattered throughout the posterior pole. The dark hypoautofluorescent regions correspond to blocked signal from intraretinal hemorrhages and areas of retinal ischemia. Hyperautofluorescent spots are observed in between, reflecting metabolic stress and dysfunction of the retinal pigment epithelium (RPE). The macular region demonstrates irregular mottled autofluorescence, consistent with underlying macular edema and structural disruption. These findings are compatible with central retinal vein occlusion and highlight the extent of retinal hemorrhage and ischemia.
The optical coherence tomography (OCT) image shows significant macular edema with marked retinal thickening. Multiple intraretinal hyporeflective cystoid spaces are present, consistent with cystoid macular edema. There is also a dome-shaped elevation at the fovea, suggesting serous detachment of the neurosensory retina. The normal foveal contour is lost, and the retinal architecture appears markedly disorganized. Hyperreflective foci are scattered within the retina, likely representing hemorrhagic or exudative material. These findings are characteristic of macular involvement in central retinal vein occlusion.



Early Phase
The early phase fluorescein angiography image demonstrates delayed venous filling with irregular and tortuous retinal veins. Areas of hypofluorescence are observed corresponding to blocked fluorescence from widespread intraretinal hemorrhages. Patchy zones of capillary nonperfusion are already visible, particularly in the posterior pole.
Mid Phase
In the mid phase, there is increasing visibility of extensive capillary dropout with marked hypofluorescent areas indicating retinal ischemia. Hyperfluorescent leakage is observed from the dilated veins and in the macular area, consistent with macular edema. The optic disc also shows early hyperfluorescence suggesting disc leakage.
Late Phase
The late phase image reveals diffuse leakage throughout the posterior pole with further intensification of hyperfluorescence in the macular region and around the optic disc. Nonperfusion areas remain evident, and the widespread leakage highlights significant breakdown of the inner blood-retinal barrier. These findings are consistent with ischemic central retinal vein occlusion.
Follow-up and Post-treatment Imaging
After the diagnosis of central retinal vein occlusion was established with multimodal imaging at presentation, the patient underwent intravitreal anti-VEGF therapy. A total of seven intravitreal injections were administered over the follow-up period.

The post-treatment color fundus photograph demonstrates significant regression of the widespread intraretinal hemorrhages seen at baseline, leaving only a few scattered residual hemorrhagic spots. The retinal veins appear less tortuous and engorged, suggesting partial restoration of venous outflow. The optic disc margin is now more distinct with reduced peripapillary edema. Notably, collateral vessels are visible on the optic disc surface, representing compensatory venous channels that have developed in response to the chronic venous obstruction. A few cotton wool spots remain in the posterior pole, reflecting localized ischemia. Overall, the retinal background is clearer, and these findings indicate a favorable anatomical response after repeated intravitreal anti-VEGF therapy.
The post-treatment OCT image demonstrates a marked reduction in macular edema with restoration of the foveal contour and resolution of intraretinal cystoid spaces. The outer retinal layers appear more distinct, and overall retinal thickness has normalized compared to baseline. Notably, there is thinning in the temporal macular region, likely reflecting atrophic changes secondary to chronic ischemia and prior edema. These findings indicate a favorable anatomical response to anti-VEGF therapy, while also highlighting residual structural damage in the temporal retina.


The ultra-widefield OCTA image provides an extended view of the retinal vasculature beyond the posterior pole. In the post-treatment scan, the superficial vascular plexus (top image) demonstrates improved perfusion centrally, although extensive areas of capillary nonperfusion are still evident in the midperiphery and periphery. The deep plexus (second one) reveals more pronounced dropout, with diffuse hypoperfused zones reflecting irreversible ischemic damage. Overall, the ultra-widefield OCTA highlights the persistent peripheral ischemia in spite of treatment, underlining the value of widefield imaging in assessing the full extent of vascular compromise in central retinal vein occlusion.
Central retinal vein occlusion (CRVO) is one of the most common retinal vascular disorders, second only to diabetic retinopathy in prevalence. It results from obstruction of the central retinal vein, typically at or near the level of the lamina cribrosa, leading to impaired venous outflow, increased intravascular pressure, and widespread retinal ischemia. The condition is strongly associated with systemic vascular risk factors such as hypertension, diabetes mellitus, hyperlipidemia, and cardiovascular disease, as well as ocular conditions like glaucoma. Clinically, patients often present with sudden, painless vision loss or blurring in one eye. Fundus examination reveals the characteristic “blood and thunder” appearance, with widespread intraretinal hemorrhages, venous dilation and tortuosity, cotton wool spots, and optic disc swelling. CRVO is classified into ischemic and non-ischemic forms, the former carrying a higher risk of complications such as neovascular glaucoma and severe, permanent vision loss.
Advances in multimodal imaging have significantly enhanced the diagnosis and monitoring of CRVO. Fluorescein angiography is used to assess retinal perfusion status, demonstrating capillary nonperfusion, delayed venous filling, and vascular leakage. Optical coherence tomography (OCT) provides detailed visualization of macular edema, the major cause of visual impairment in CRVO, while OCT angiography (OCTA) allows noninvasive assessment of the retinal microvasculature and capillary dropout. Management focuses on intravitreal pharmacotherapy, primarily anti-vascular endothelial growth factor (anti-VEGF) injections, which have become the gold standard for reducing macular edema and improving vision. Corticosteroid implants may be considered in refractory cases, while panretinal laser photocoagulation is reserved for ischemic CRVO complicated by neovascularization. Despite treatment advances, long-term visual prognosis remains variable, depending largely on the degree of ischemia and response to therapy.
Credit: M. Giray Ersoz, MD, FEBO
Biruni University School of Medicine, Department of Ophthalmology, Istanbul, Turkey
Instagram accounts: @retina.review and @retina.dr.girayersoz
and Sepideh Lotfi, MD
Biruni University School of Medicine, Department of Ophthalmology, Istanbul, Turkey
Instagram accounts: @sepidls

